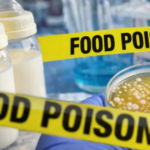

ونقلت الهيئة البث عن مسؤولين إسرائيليين قولهم إنه “في حال وقوع هجوم على إيران سيتم إبلاغ المواطنين مسبقا وبشكل كاف”.
كما نقلت الهيئة عن مصدر أمني: “لا يوجد حاليا أي تنسيق عملياتي بشأن إيران، موقف الرئيس دونالد ترامب غير واضح”.
والخميس، قال ترامب، إن “قوة عسكرية هائلة تتجه نحو إيران”، التي قال إنه “يراقبها عن كثب”.
وفي تصريحات على متن طائرة الرئاسة الأميركية، أكد ترامب أنه هدد إيران بضربة إذا أجرت إعدامات، لكنه أشار إلى أنه “أوقف 837 عملية إعدام”.
وأوضح الرئيس الأميركي: “لدينا الكثير من السفن في طريقها إلى المنطقة. كما أن لديناحاملة طائرات متجهة إلى هناك أيضا. سنرى ما الذي سيحدث. لا أريد أن يحدث أي شيء، لكن سيتعين علينا أن نرى ما سيحدث”
وقال مسؤول إيراني كبير الجمعة إن إيران ستتعامل مع أي هجوم على أنه “حرب شاملة ضدنا”، وذلك قبل وصول مجموعة حاملة طائرات عسكرية أميركية ضاربة وغيرها من المعدات العسكرية إلى منطقة الشرق الأوسط في الأيام المقبلة.
وأضاف المسؤول الذي تحدث لـ”رويترز” شريطة عدم الكشف عن هويته “هذا الحشد العسكري – نأمل ألا يكون الهدف منه مواجهة حقيقية – لكن جيشنا مستعد لأسوأ السيناريوهات. هذا هو السبب في أن كل شيء في حالة تأهب قصوى في إيران”.
وتابع: “هذه المرة سنتعامل مع أي هجوم سواء كان محدودا أو شاملا أو ضربة دقيقة أو استهدافا عسكريا مباشرا، أيا كان المسمى الذي يطلقونه عليه، على أنه حرب شاملة ضدنا، وسنرد عليه بأقوى طريقة ممكنة لحسم هذا الأمر”.